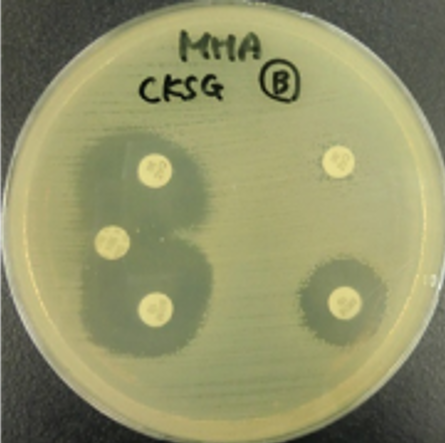
ディスク検査の写真

目的から探す
ホーム > 健康・医療・福祉 > 健康 > 健康づくり・病気予防 > 衛生研究所 > 公衆衛生情報トピックス > 茨城県衛生研究所における薬剤耐性菌の検査状況について(2025年)
ページ番号:74551
更新日:2026年2月24日
ここから本文です。
茨城県衛生研究所における薬剤耐性菌の検査状況について(2025年)
検査の概要
1980年以降、これまでの抗菌薬が効かない細菌(薬剤耐性菌)が世界中で増えてきました。何も対策を取らない場合、2050年には薬剤耐性菌によって世界で年間1,000万人が死亡すると予想されています。
現在、カルバペネム系抗菌薬は、幅広い細菌に効果があると言われていますが、この抗菌薬が効かないカルバペネム耐性腸内細菌目細菌(CRE)による感染症は、治療が困難とされます。CREの中でもカルバペネマーゼ産生腸内細菌目細菌(CPE)は、他の細菌に薬剤耐性遺伝子を伝達するリスクがあり、特に警戒が必要です。
当所では、県内におけるCRE感染症の実態把握及びまん延防止を目的として、県内で検出されたCRE菌株を収集し解析しています。
検査状況
2019~2024年度においてCREを498株収集し、以下のとおり検査を実施しました。
- 質量分析計による菌種同定
- 遺伝子検査(図1)及びディスク検査(図2)によるCPE判別
- シークエンス解析(遺伝子解析)によるカルバペネマーゼ遺伝子型別
 |
|
| 図1 遺伝子検査 | 図2 ディスク検査 |
結果
菌種の内訳
当所に搬入されたCREの菌種は、Klebsiella aerogenesが最も多く、次にEnterobacter cloacae complexが多いことが分かりました(図3)。これは、全国の検出状況と一致していました。
 |
| 図3 搬入された菌株の菌種(498株) |
カルバペネマーゼ遺伝子型の内訳
CRE 498株のうち、CPEは29株(5.8%)検出されました。カルバペネマーゼ遺伝子型は、IMP-1(21株)、IMP-6(2株)、NDM-5(6株)でした(図4)。
本県で最も多く検出されたIMP-1は、全国でも一番多く検出され、IMP-6は、西日本地域を中心に検出されています。
NDM-5は、海外型のカルバペネマーゼ遺伝子型と言われていますが、近年、本県を含め全国の海外渡航歴の無い患者から検出されています(表1)。
 |
| 図4 遺伝子型別カルバペネマーゼ検出地域 |
| 表1 カルバペネマーゼ遺伝子型の特徴 |
 |
研究結果から本県のCPE検出率は、全国の15%程度と比較して低いものの、複数の薬剤耐性遺伝子が検出され、薬剤耐性菌の潜在的リスクが示唆されました。